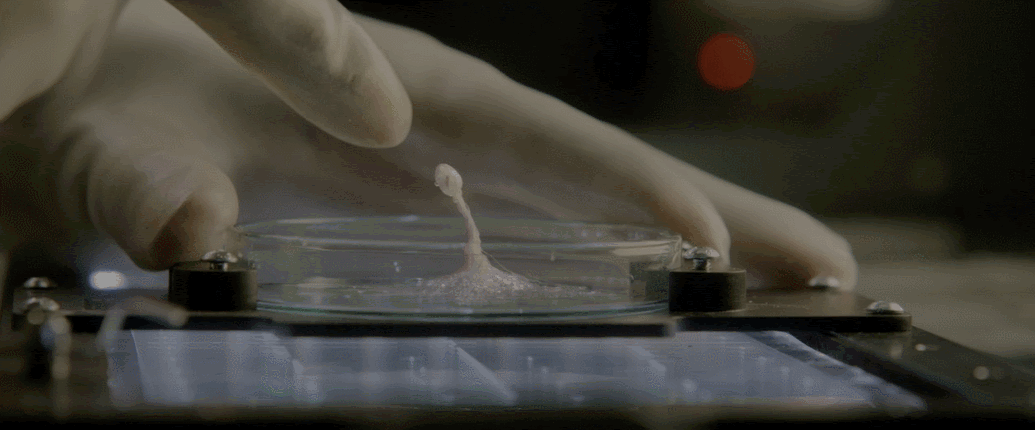

《异星觉醒》里的卡尔文 拥有超越水熊虫的抗性 智商还可能高过人类
《异星觉醒》里的卡尔文 拥有超越水熊虫的抗性 智商还可能高过人类
上篇我们讲的是《极度深寒》里的奥物瓦类(童年阴影),有人说《异星觉醒》其实就是《极度深寒》的前传(说说而已),所以这篇我们来介绍下怪物编号:0011——卡尔文。

卡尔文全名Calvin,火星异种。由于它的原型是地球上的黏菌(细分支盘基网柄菌“Dictyostelium”),所以卡尔文暂定为单鞭毛生物-变形虫门 (起码卡尔文初始形态非常像黏菌,但它往后发展就不好定义生物分类了,好像它为了适应环境,可以进化成完全不同的形态。)

卡尔文外观目前主要分为三种形态。第一:初始形态,这一阶段它与黏菌的外形非常像,它们徘徊于微生物与多细胞生物之间,既可以以单细胞形态存在,也可以聚集之后形成多细胞结构。

黏菌
群体之间以化学引诱物为信号,达到整体行动的目的。关键是这个整体,还会分化出不同的子体,构成多细胞结构的不同组成部分。

第二:适应体,这一阶段卡尔文已经初步适应了外在环境,形成了最基础的器官。片中它拥有了薄膜状的肢体(环境不同应该会呈现出不同的样子),看上去像一只透明的大海星。


第三:初级战斗体,卡尔文初步适应环境后,马上要做的便是猎食,以便获取更多能量,发展自身。片中卡尔文又进化出了几条触手,以及锋利的口器。

卡尔文每个细胞都拥有完整的感知系统、肌肉系统以及神经系统和智力。且每个细胞都携带大量遗传信息,可以根据需要进化出各种功能器官。所以它的自愈能力几乎和金刚狼不相上下,前提是体内储备足够多的能量(食物),从《异星觉醒》分析它吃下去的食物,几乎百分百转化成了它需要的能量。(因为在片中透明的它只进不出,体型还在飞速增长)

不仅自愈力强,它还拥有极强的物理以及元素抗性,强大到太空辐射以及真空环境都无法影响到它的肉体。其次片中的枪械、电击以及火焰喷射器,都未对其产生有效伤害。地球目前抗性最强的生物是水熊虫,资料显示它可以生存于151 °C的高温环境,也可以存在于-272℃的绝对零度中,它还能在1200个大气压下存活(可以理解为720吨重量)以及超过5000Gy的辐射(人类极限5-10),此外它不怕真空不怕缺水,在极端环境时就会进入假死状态。

烧不死的卡尔文
而卡尔文的抗性甚至超过水熊虫这种变态生物。(是不是有点琦玉的感觉啦)
再退一万步说,大口径武器将卡尔文撕成碎片,但它却拥有魔人布欧一般的生命力,只要还有一个细胞存在,它就能复活。

卡尔文使用工具 高等智慧表现之一
关键是卡尔文并不是肌肉莽夫,它的全体智力甚至超过人类,所以暗度陈仓这一手它应该玩得很溜。(有人可能会质疑,它的单细胞需要在特定环境下才能激活,其实那是因为卡尔文已经进入休眠状态了,如果只是将它击碎,是不可能让它忽然休眠的)

前文提到了卡尔文每个细胞都具备智力,而群体就形成了类似超多核计算机一般变态的运算能力。按照这样分析,只要拥有足够多的细胞,它的智力很可能达到人类无法理解的程度。(类似强人工智能,还是会进化的那种)所以卡尔文绝对不算是一只野兽,它是生物科技树点满的高智慧外星生物。



地球科学家发现黏菌群体,能快速做出有利于群体发展的判断,这种判断所消耗的时间某种程度上已超越人类现有文明。

最后说说卡尔文的攻击能力,它的每个细胞即是大脑又是肌肉,所以力量大到超出人类想象。片中开头一幕,初始形态的卡尔文就有能力绞断一个成年男性的手,这力量至少超过1000牛顿(102公斤),而这还只是它最弱的时期,可以想象它掉到地球海洋里,获得大量能量后,卡尔文绝对有灭世的能力。

而且卡尔文还有一项十分可怕的能力,它可以由单细胞组成强大的整体,自然也可以化整为零,以单细胞的状态攻击敌人,也就是说人类一旦和它对上,对付的不仅是肉体超强体型巨大的卡尔文,还有微生物层面的它。